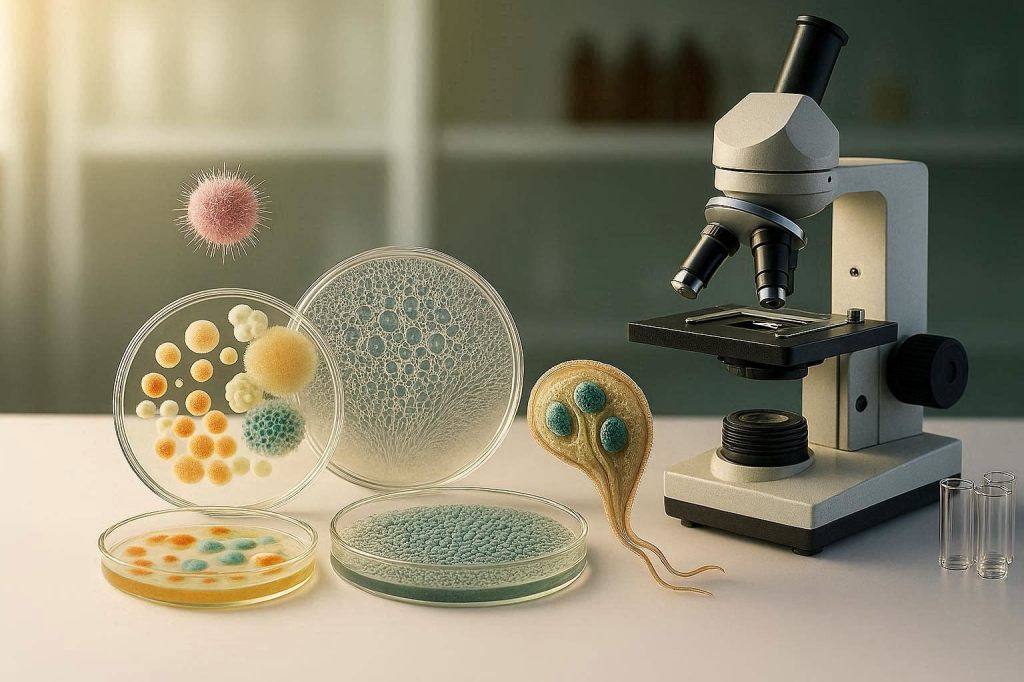

Unsere Fachbereiche und Aufgaben im Überblick
Die Labordiagnostik ist ein innovatives und technologisch geprägtes Arbeitsfeld.
Auf Grundlage des neuen Berufsgesetzes arbeiten medizinische Technologinnen und Technologen in modernen Strukturen und übernehmen verantwortungsvolle Aufgaben bei der Analyse von Proben mithilfe automatisierter Verfahren. Du arbeitest als Bindeglied der Bearbeitungskette in einem vielfältigen Team mit weiteren MT-L, Laborärzten, Forschern und bereichsübergreifendem Personal zusammen. Dein Fachwissen entwickelt sich mit den neuesten medizinischen und technologischen Erkenntnissen weiter – so bleibst du immer am Puls der Zeit.
Dich erwarten vielfältige und verantwortungsvolle Fachbereiche:
Klinische Chemie, Hämatologie, Hämostaseologie

Die Klinische Chemie umfasst die Analyse der Bestandteile des Blutes sowie weiterer Körperflüssigkeiten. Ziel der diagnostischen Untersuchungen ist es, festzustellen, ob die Konzentrationen einzelner chemischer Substanzen und die biochemischen Prozesse im Körper im Gleichgewicht sind oder krankhafte Veränderungen vorliegen. Untersucht wird vor allem der zellfreie, flüssige Anteil des Blutes – das sogenannte Serum oder Plasma – der mithilfe automatisierter Messverfahren auf eine Vielzahl unterschiedlicher Inhaltsstoffe analysiert wird. Dazu zählen beispielsweise Proteine, Hormone, Enzyme, Stoffwechselprodukte, Elektrolyte sowie von außen zugeführte Substanzen wie Medikamente.
KI-generiertes Bild, erstellt mit Bing Image Creator


Die Hämatologie befasst sich mit der Lehre und den Erkrankungen des Blutes und der blutbildenden Organe. Der Fachbereich untersucht den Anteil vorhandener Zellen im Blut sowie mögliche krankhafte Veränderungen von Zellen. Im Mittelpunkt stehen die Untersuchung der verschiedenen Blutzellen – also rote Blutkörperchen (Erythrozyten), weiße Blutkörperchen (Leukozyten) und Blutplättchen (Thrombozyten) – sowie deren Anzahl, Form und Funktion. Bei Auffälligkeiten werden die Zellen mikroskopisch genauer beurteilt. Dabei werden ihr Verhältnis zueinander sowie ihre Form und Struktur differenziert betrachtet. Die gewonnenen Analyseergebnisse der Hämatologie dienen der Diagnose und Verlaufskontrolle von Erkrankungen wie Anämien (Blutarmut), Gerinnungsstörungen (Wundstillungsstörungen) oder Leukämien (Blutkrebs) und liefern damit wichtige Grundlagen für therapeutische Entscheidungen.
Ein wichtiger Teilbereich der Klinischen Chemie und Hämatologie ist die Hämostaseologie (Gerinnung). Sie beschäftigt sich mit der Blutstillung – also damit, wie der Körper Blutungen stoppt und Wunden verschließt. Dabei kann man im Labor zwei Bereiche untersuchen: die zelluläre Gerinnung, bei der vor allem die Blutplättchen (Thrombozyten) eine Rolle spielen, und die plasmatische Gerinnung, bei der verschiedene Gerinnungsfaktoren im Blutplasma zusammenwirken. Solche Untersuchungen sind wichtig vor Operationen, bei Verdacht auf Gerinnungsstörungen wie die Hämophilie oder zur Kontrolle von gerinnungshemmenden Medikamenten wie Marcumar. Ziel ist es, Blutungsrisiken zu erkennen, Thrombosen vorzubeugen und Therapien sicher zu überwachen.
Immunhämatologie
In der Immunhämatologie beschäftigt sich das Fachpersonal mit den menschlichen Blutgruppensystemen, ihren Eigenschaften und der Verträglichkeit von Blutbestandteilen aus Spenderblut. Ziel ist es, sichere Bluttransfusionen zu ermöglichen und mögliche Komplikationen zu vermeiden. Eine Bluttransfusion wird notwendig, wenn einem Menschen wichtige Blutbestandteile fehlen. Das kann lebensbedrohlich sein und muss schnell ausgeglichen werden. Ursachen dafür sind zum Beispiel große Blutverluste, schwere Erkrankungen, Störungen der Blutbildung oder bestimmte immunologische Prozesse im Körper. Blut ist ein komplexes und individuelles Organ – so einzigartig wie jeder Mensch. Sind die Blutbestandteile von Spender und Empfänger nicht kompatibel, kann das schwerwiegende, wenn nicht sogar lebensbedrohliche Folgen haben. Die verantwortungsvolle Arbeit in der Blutbank stellt daher sicher, dass Maßnahmen in diesem Bereich durch Austestungen sorgfältig geprüft werden und die Bluttransfusion möglichst risikofrei durchgeführt werden kann.

KI-generiertes Bild, erstellt mit Bing Image Creator
Mikrobiologie
Wir sind nicht allein auf der Welt – das gilt auch für unseren eigenen Körper. Überall um uns herum und sogar auf und in uns leben winzig kleine Organismen, die mit bloßem Auge nicht sichtbar sind. Genau mit dieser faszinierenden, oft verborgenen Welt beschäftigt sich die Mikrobiologie. Das medizinische Labor untersucht die Vielfalt dieser Mikroorganismen: Bakterien, Viren, Pilze und Parasiten. Dafür züchten wir bestimmte Erreger auf speziellen Nährmedien an oder betrachten Mikroorganismen mit modernen Laborverfahren ganz genau, um sie sichtbar zu machen und eindeutig zu identifizieren. Manche von ihnen sind harmlos oder sogar nützlich – andere können Krankheiten verursachen. Unsere Aufgabe ist es, diese Krankheitserreger zuverlässig zu erkennen und Ärztinnen und Ärzte bei der richtigen Behandlung zu unterstützen.
KI-generiertes Bild, erstellt mit Bing Image Creator
Serologie, Molekulargenetik

In der Serologie untersuchen Labormitarbeiterinnen und Labormitarbeiter das Blut von Patientinnen und Patienten – genauer gesagt: den nicht-zellulären Anteil, das Blutserum. Dabei geht es vor allem um eine wichtige Frage: Wie reagiert das Immunsystem auf Krankheitserreger? Wenn unser Körper mit Viren, Bakterien oder anderen Fremdstoffen in Kontakt kommt, bildet er spezielle Abwehrstoffe, sogenannte Antikörper. Diese Antikörper sind wie „Erkennungszeichen“: Sie zeigen, ob eine Infektion aktuell besteht, bereits überstanden wurde oder ob ein Impfschutz vorhanden ist. Mit modernen Analysegeräten und speziellen Testverfahren können wir jedoch nicht nur Antikörper nachweisen, sondern teilweise auch bestimmte Strukturen von Erregern selbst – sogenannte Antigene. Dadurch lässt sich in manchen Fällen direkt feststellen, ob Bestandteile eines Krankheitserregers im Körper vorhanden sind. So können wir zum Beispiel erkennen: ob eine Infektionskrankheit vorliegt oder durchgemacht wurde, ausreichender Impfschutz besteht, das Immunsystem richtig funktioniert oder ob bestimmte Erkrankungen vorliegen, bei denen sich das Immunsystem gegen die eigenen Strukturen im Körper richtet (Autoimmunerkrankungen).
Die Analyse des Erbguts (DNA) steht in der Molekulargenetik im Vordergrund. In medizinischen Laboren werden solche Tests zum Beispiel eingesetzt, um Erbkrankheiten nachzuweisen, Infektionserreger wie Viren oder Bakterien zu identifizieren oder bestimmte Tumorveränderungen zu untersuchen. Eine bekannte Methode ist die sogenannte PCR (Polymerase-Kettenreaktion). Mit ihr können selbst kleinste Mengen genetischen Materials vervielfältigt und sichtbar gemacht werden. So lässt sich zum Beispiel feststellen, ob bestimmte Krankheitserreger im Körper vorhanden sind oder ob genetische Veränderungen vorliegen.
Histologie, Zytologie

Im Labor des Fachbereichs Histologie und Zytologie dreht sich alles um die Untersuchung von Zellen und Geweben. Diese Arbeit ist ein wichtiger Bestandteil der Diagnostik in der Pathologie (Lehre von Krankheiten). Auch hier wird unter dem Mikroskop sichtbar gemacht, was dem bloßen Auge verborgen bleibt – zum Beispiel Entzündungen oder Tumorerkrankungen. Die Histologie befasst sich mit der Untersuchung von Gewebeproben. Diese Proben stammen beispielsweise aus Operationen oder Biopsien. Im Labor werden sie sorgfältig vorbereitet, in hauchdünne Schnitte geschnitten, gefärbt und anschließend mikroskopisch analysiert. So können Ärztinnen und Ärzte eine genaue Diagnose stellen. Die Zytologie konzentriert sich auf einzelne Zellen. Zellproben – zum Beispiel aus Abstrichen oder Körperflüssigkeiten – werden aufbereitet und unter dem Mikroskop beurteilt. Auch hier geht es darum, krankhafte Veränderungen frühzeitig zu erkennen.
KI-generiertes Bild, erstellt mit Bing Image Creator